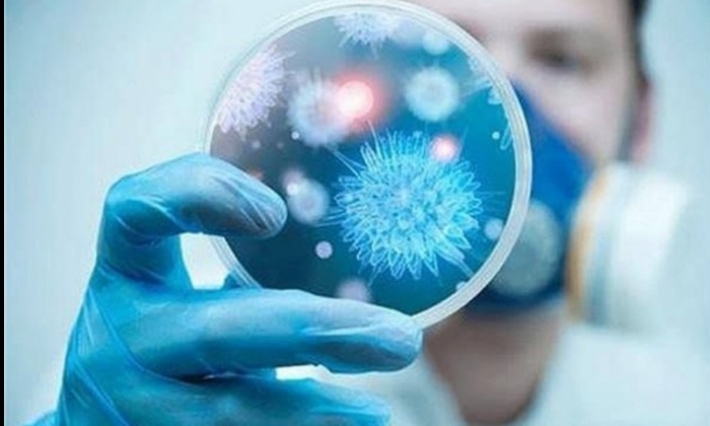
بنزرت: عزل ذاتي لـ 16 مواطنا جاؤوا مع أول مصاب بكرونا على نفس الباخرة

إعلانات
بنزرت: عزل ذاتي لـ 16 مواطنا جاؤوا مع أول مصاب بكرونا على نفس الباخرة
تم، مساء أمس الثلاثاء 4 مارس، إخضاع 16 مواطنا من ولاية بنزرت، من العائدين من إيطاليا يوم 27 فيفري الفارط على متن الباخرة التي أقلت أول مصاب بفيروس "كورونا"(في تونس)، للعزل الذاتي بمنازلهم، وفق ما ذكره المدير الجهوي للصحة جمال الدين السعيداني.
وأضاف المصدر ذاته، أنه لم تظهر على هؤلاء المواطنين أية علامة من علامات الاصابة بفيروس "كورونا"، وهم في صحة جيدة، واشار إلى أنه تم تقديم النصائح لهم لمساعدتهم على توخي الحذر، وتنفيذ خطة العزل لمدة 14 يوما.










